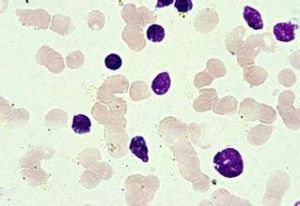
血小板減少

病症特點
 血小板
血小板婦女病人,缺乏大多數人都存在的血小板抗原(PLA-1).供血中的PLA-1-陽性血小板激發產生抗-PLA-1抗體,這些抗體能與病人自身的PLA-1-陰性血小板起反應.所發生的嚴重的血小板減少症,要持續2~6周始緩解.藥物有關的免疫性血小板減少症(如奎尼丁和奎寧誘發ITP),除有服藥史外,症狀與ITP相同.停用藥物後,血小板計數在1~7天內開始回升.而金鹽所引起的血小板減少症卻是例外,因為注入的金鹽可在體內保存許多星期。
中藥處方
處方一
【辨證】風火熱毒,傷其血絡,營血瘀滯,淫於腠。
【組成】犀角3克,生地30克,丹皮10克,赤芍10克,白薇10克,紫草10克,知母10克,沙參10克,生槐花30克,大青葉10克,板藍根15克。
【出處】譚家興方。
處方二
【藥方名稱】卷柏紫癜方
【主要成分】精選卷柏、太子參、銀柴胡、丹皮、山萸肉、茯苓等十幾味天然野生藥材配伍而成。
【性狀規格】飲片及藥粉,袋裝。
【功能主治】淨血止血,消除紫癜,提升血小板,寧心安神,解表散邪,針對治療血小板減少性紫癜及其併發症。
【用法用量】將方中飲片及藥粉包置於砂鍋內,加水1000~1200毫升,浸泡5分鐘後,直接用大火煎至水沸,再以小火煎藥30分鐘即可服用。每日一付,分三次服用,每次一碗為宜,十五付為一療程。
【注意事項】
血小板減少
血小板減少2、將一半藥材放入砂鍋內;然後將秘藥包[1]里的藥粉倒於煎藥袋內,紮緊袋口同置入煎藥鍋內,再將剩餘藥材倒入,使藥粉包處在藥材中間,最後將整體藥材壓緊,配以約1200ml水浸泡5分鐘後煎煮。(注意:壓緊藥材後,所加的水浸沒藥材就好,約1200ml即可,水不宜過多或過少。);
3、煎煮時掌握好火候和煎藥時間,先以大火煮沸,接著以文火煎煮30分鐘即可;
4、將藥汁倒出,分為三碗,每碗120ml-150ml左右;分別為飯後半小時服用。藥液可置入冰櫃保存,服用時加熱。
5、每日一付,每次一碗為宜,十五付為一療程。
處方三
【辨證】脾陰虛,血燥,陰虛生內熱,熱傷絡脈則血外溢。
【治法】養陰益脾,潤燥,佐以清熱,化斑。
【方名】加味脾陰煎。
【組成】生地10克,生白芍30克,旱蓮草15克,山藥20克,蓮米15克,連翹10克,赤小豆30克,黃連6克,淡竹葉10克,五味子10克,棗皮10克,大棗10個,炙甘草10克。
【用法】水煎服,每日1劑,日服2次。
【出處】袁尊山方。
中藥處方(四)
【辨證】血瘀於肌腠。
【治法】活血化瘀,佐以補脾滋腎。
【方名】加減紫癜方。
【組成】雞血藤15克,丹皮15克,茜草15克,當歸15克,大棗10克,茅根15克,旱蓮草20克,三七粉5克(沖服),仙鶴草20克,山梔15克。
【用法】水煎服,每日1次,日服2次。
血小板減少的病人在飲食上要保證各種營養成分的供給,宜多食富含優質蛋白質、多種維生素和含微量元素鐵較多的蛋類、牛奶、豆類、新鮮、蔬菜和水果、海產品等。食療原則以補氣養血,滋陰涼血、止血為主。
血小板減少分成三種,飲食也有所不同。
實熱型:
飲食宜清涼之品,可以進食綠豆湯、兔肉、田螺、香蕉、甘蔗、橄欖、藕、冬瓜、絲瓜、通菜、黃花菜、茭白等清解毒熱之物,忌食或少食羊肉、狗肉、牛肉、雞肉、驢肉、雀肉、水龜肉、胖頭魚、黃花魚、荔枝、楊梅、核桃仁、杏、辣椒、花椒、胡椒、蒿子桿、大蒜、芥菜、榨菜、丁香、茴香菜等性溫、辛熱之品,以避免發生紫斑連片,使毒熱更盛。
虛熱型:
飲食宜涼潤之品,可以進食鳳梨蜜、柿子、絲瓜、菠菜、通菜、藕、蚌、銀耳、木耳、貓肉、青魚、黑魚、鱉、干貝、河蟹、水龜肉、銀魚、鴨肉等滋陰涼血之物,以輔助治療。忌服或慎用溫散、燥熱、助陽之品,以避免發生出血量多,及心煩急躁、不得安寧等虛熱迫擾之證。
氣虛型:
飲食宜甘溫之物,可以進食牛肉、羊肉、鴿肉、海參、龍眼肉、蠶豆、栗子、大棗、南瓜、山藥、甘薯、蓮子、青梅等益氣攝血之品;忌食或少食河蟹、牡蠣、蚌、生菱角、冬瓜、葫蘆、苦瓜、茭白、香蕉等性涼、損氣之物以避免發生氣短、身倦、神疲、血出不止等氣不攝血之證。
“是藥三分毒”。下面介紹幾則“升高血小板、白細胞”的食療藥膳:
1)龍眼棗米粥--花生米、大棗各30克、龍眼肉10克、粳米50克,同煮粥食用。
2)鱉肉脊髓湯--鱉肉250克、姜1克、蔥3克、豬脊髓200克,鱉肉、蔥、姜少許煮熟後,再加入腦脊髓。煮20分鐘後,加入食鹽、醬油調味食用。
3)牛肉鵪鶉湯--鵪鶉(去毛及腸雜,洗淨)1隻、牛肉250克、小麥50克,鵪鶉、牛肉、小麥同煮,加入少量食鹽調味,即可食用。
4)鴨肉大米粥--鴨肉100克、大米100克,鴨肉切片與大米同煮粥,用食鹽調味食用。
5)黃芪烏雞湯--黃芪40克、烏雞肉600克,黃芪、烏雞肉、食鹽、水適量,同蒸熟食用。
注意事項
1、血小板減少性紫癜是一種免疫綜合徵,是常見的出血性疾病。特點是血循環中存在抗血小板抗體,是血小板破壞過多,引起紫癜;而骨髓中巨核細胞正常或增多,幼稚化。
2、血小板主要是起止血凝血功能的,血小板過低會有自發性出血的可能,輕者皮下出血,也就是皮膚紫癜或是牙齦出血,鼻出血,嚴重就是內臟出血,是有生命危險的。
3、此病與人體免疫機制缺陷有很大關係,免疫系統失衡紊亂導致的發病,病情也是不斷變化的,此病醫學上又稱為免疫性血小板減少。
4、西醫治療方案:激素,丙球(免疫球蛋白),免疫抑制劑,輸注成分血小板,切脾,全國各地都一樣,一般可以起到一定的緩解病情的作用,但達不到治本,而且激素和免疫抑制劑長期使用對身體副作用很大,隨著藥物的減量或是停用,血小板還是會下降的;丙球也只能是維持一周到半個月的左右,部分患者有效時間只有幾天,藥物停用,血小板還是會下降的;不建議多次輸注成分血小板,會使血小板自身產生抗體,從而加速血小板的破壞。
 避免菸酒
避免菸酒6、血小板太低時必須住院治療的,如您的血小板不足10,是必須住院治療,不然會危及生命的的。雖然您現在是活蹦亂跳的,但是還是建議您定期複查血常規。
7、血小板減少患病期間注意事項:
1)患病期間注意飲食衛生,注意飲食習慣,避免生冷辛辣對身體刺激性強的食物,避免菸酒,注意休息,不能做劇烈運動,避免感冒,避免磕碰,保持情緒舒暢;
2)飲食以高蛋白、高維生素及易消化飲食為主。避免進食粗硬食物及油炸或有刺激的食物,硬質纖維食物(如芹菜),容易引起上火的食物(如牛羊肉),以免易形成口腔血泡乃至誘發消化道出血。多食含維生素C、P的食物。有消化道出血時,更應注意飲食調節,要根據情況給予禁食,或進流食或冷流食,出血情況好轉,方可逐步改為少渣半流、軟飯、普食等。同時要禁酒;
3)儘可能避免使用引起血小板減少的藥物,如利福平,阿司匹林、奎寧、頭孢菌素、洋地黃毒甙等;
4)平時要保持心情舒暢,避免精神過度緊張,要保持個人衛生,預防各種感染和感冒,防止外傷。

